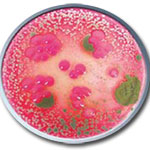

V dnešnej dobe patrí klimatizácia k štandartnej výbave skoro každého automobilu. Každého z nás pri kúpe nového alebo ojazdeného automobilu zaujíma, či je vybavené funkčnou klimatizáciou. No málokto z nás si uvedomuje, aká dôležitá je starostlivosť o údržbu autoklimatizácie.
Pre dokonalejšie čistenie celého systému ventilacie vozidla, používame ultrazvukový vyvíjač a generátor ozónu.

V znečistenom filtry a výparníku sa množia nebezpečné baktérie a víry, ktoré sa potom dostávajú ďalej do systému klimatizácie. Z tadial sa šíria do interieru automobilu a ohrozujú zdravie cestujúcich.
Čistenie a plnenie autoklimatizácie vykonávame na profesionálnych automatických zariadeniach. Pri čistení prebiehajú následovné úkony: odsatie a recyklácia chladiaceho média, vákuovanie a test tesnosti klimatizácie, vstrek oleja a aditív, plnenie okruhu autoklimatizácie a na záver test prevádzkového tlaku celého klimatizačného systému

Zachytávajú nečistoty ako je peľ, pachy, ozón i SO2 a tým zabraňuje ich prenikaniu do ventilácii. Životnosť filtra výrazne ovplyvňujú podmienky pri činnosti vozidla.

Zanesený kabínový filter obmedzuje pretekajúce množstvo vzduchu a tým znižuje účinnosť ventilácie. Pravidelná výmena je nevyhnutná pre správnu funkciu celého systému.

Poškodený či zašpinený filter prepúšťa nečistoty do systému, v ktorom potom dochádza k ich nahromadeniu a následne k nežiadúcim hnilobným procesom a rastu pliesní.

Zanedbaná klimatizácia nefúka do vnútorného priestoru automobilu len čerstvý vzduch. K cestujúcim sa tak dostáva i množstvo mikroorganizmov ohrozujúcich zdravie.

Výparníky ochladzujú vzduch prúdiaci do automobilu. Sú jednou zo základných častí klimatizačného systému a výrazne tak ovplyvňujú jeho správnu funkciu.

Znečistený výparník sa prejavuje zníženou účinnosťou a nepríjemným zápachom pri činnosti, pripadne po vypnutí klimatizácie. Predísť tomu ide pravidelným čistením.

Pliesne, ktoré sa na výparníkoch vytvárajú a ktoré sa môžu dostať do ventilácie, sú nebezpečné pre ľudské zdravie. Pravidelná údržba je preto nevyhnutnou súčasťou prevencie.
Laboratórny pohľad na vzorku odobraný z prieduchu rok a pol starého Porsche pred vykonaním dezinfekcie.
Kompresor je hlavný a pritom najchúlostivejšou časťou klimatizácie. Jedine správna údržba a použitie správneho typu oleja zamedzí zníženie jeho životnosti.
Nesprávny olej v systéme sa odlučuje od chladiva, preto nedokáže zaručiť spoľahlivé mazanie kompresoru vo všetkých režimoch
Nevhodný olej alebo nedostatok oleja vedie k poškodeniu kompresoru a tým i k oprave celého klimatizačného systému Tomu ide ale jednoducho predísť pravidelným servisom.
Pre zachovanie mazacích schopností tepelne vysoko namáhaných olejov je nevyhnutná ich výmena v pravidelných intervaloch daných výrobcom. Inak dochádza k poškodeniu kompresora.
Hlavným účelom kondenzátora je ochladiť médium, čím zaručuje správnu funkciu celého systému klimatizácie v automobile.
Zašpinený alebo poškodený kondenzátor nedokáže správne ochladiť chladiaci médium, tým zbytočne dochádza k nadmernému namáhaniu a opotrebeniu kompresora.
Nedostatočné ochladenie média zvyšuje pracovný tlak klimatizácie a tým i spotrebu pohonných hmôt.
Slúžia ako filtre na olej s chladivom a zároveň zachytávajú nežiadúcu vlhkosť v systéme. Ich životnosť je limitovaná, a preto je nutná pravidelná výmena.
Starý sušič už nepohlcuje vlhkosť, ktorá poškodzuje olej a to vedie k vydraniu kompresora. Na snímke rez sušičom, v ňom poškodený olej zanechal šedý film takto uvolnených mikročastíc.
Absorbcia vlhkosti je chemicky, nanávratný proces. Pre správnu funkciu je nutné sušič najneskor po štyroch rokoch vymeniť!

Pre správnu funkciu klimatizácie je nutná pravidelná údržba.. Vyčistenie celého systému a výmena kabínového filtra by mala byť prevedená 2x ročne, výmena oleja a chladiva najmenej 1x ročne.